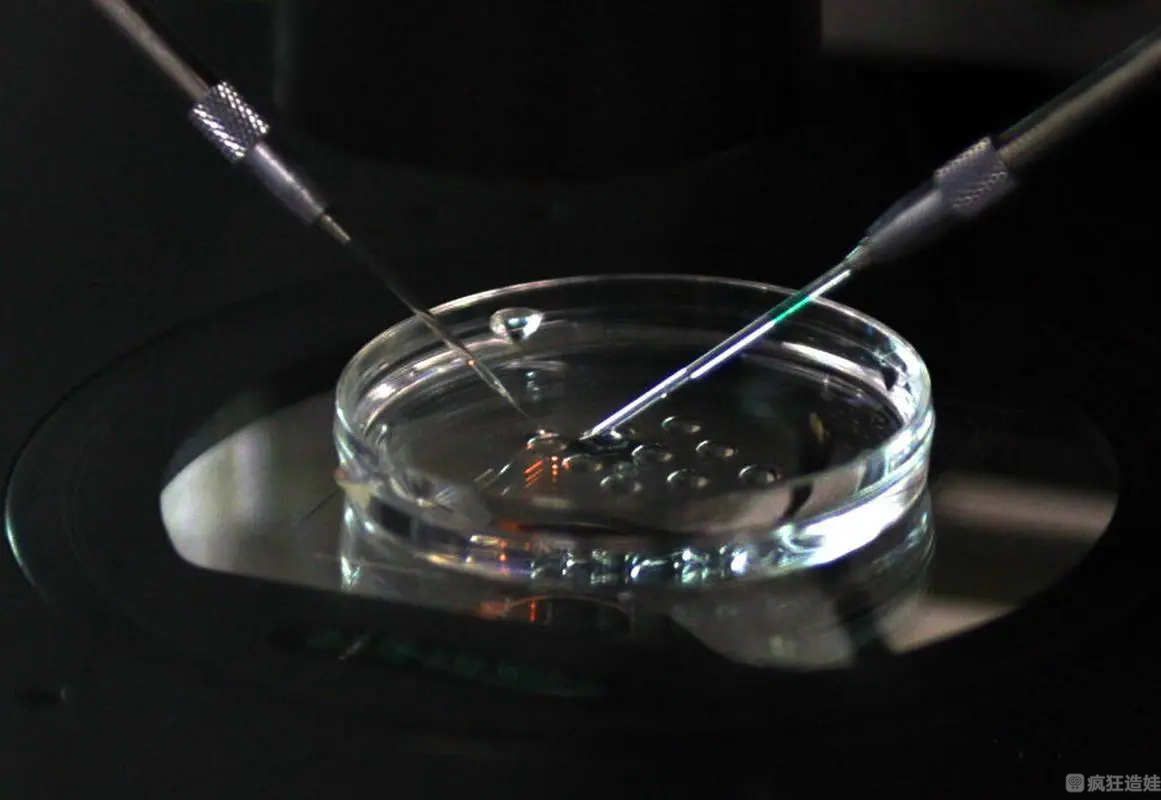
第三代试管婴儿移植胚胎怕热吗？移植后胚胎会被热坏吗？

-

孕妇怕冷或怕热生男宝还是女宝?
孕期怕冷怕热看男女 对于孕妈妈而言,肚子里的宝宝是男是女,成为她们茶余饭后最大的谈之和乐趣。大家都会根据孕妇身体的一些变化来判断,至于说法那自然是五花八门的。听..
2023-02-25 12:08 -

孕妇怕热是怎么回事?孕妇怕热正常吗
不知道准爸爸们有没有发现,女人在怀孕之后越来越怕热,明明怀孕前都没那么怕热的,这是怎么回事,怀孕期间怕热正常吗?孕妇怕热是怎么回事第一个原因就是激素的影响相信很..
2023-06-15 08:57 -

孕晚期怕热是怀男孩女孩?为何有人会认为孕晚期怕热与性别有关?
怀孕是每个女性生命中的一段特殊旅程。在怀孕期间,女性经历了身体和心理上的种种变化。其中之一就是孕晚期的症状,如怕热。这让人不禁联想到一个常见的困惑:孕晚期怕热是..
2024-10-09 09:15 -
第三代试管婴儿移植胚胎怕热吗?移植后胚胎会被热坏吗?
在做的时候,很多女性朋友都会变成全家人的焦点之一,捧在手里怕摔了,含在嘴里怕化了。但到了最后胚胎移植的时候,这种照顾反而会成为担心的理由,由于害怕出现着凉等情况..
2025-07-18 10:38
微信分享
扫描二维码分享到微信或朋友圈